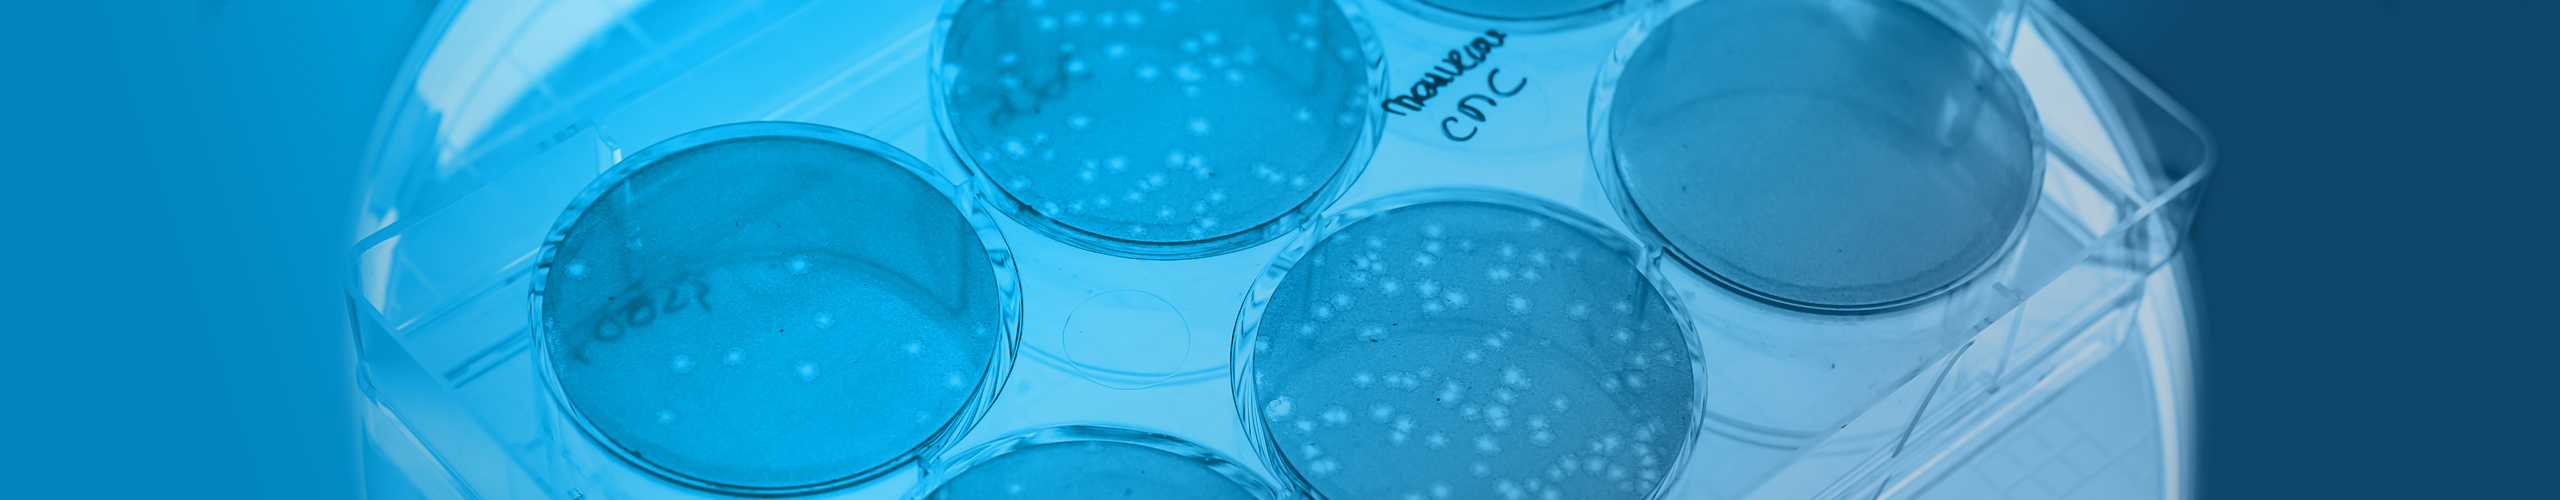

CONTRÔLE QUALITÉ
Le calendrier de vos projets et vos rendez-vous avec les autorités de santé sont au centre de notre attention.
Le département analytique de notre site de Strasbourg est le centre d’excellence pour accompagner vos projets, tant pour la substance active que le produit fini.
Nos spécialistes analytiques sont polyvalents:
- Nous contribuons à la mise en place d’un package analytique robuste
- Nous vous aidons dans le choix des méthodes analytiques pertinentes et indispensables à la caractérisation de votre produit et des impuretés liées au procédé
- Nous qualifions et validons les méthodes analytiques.
Notre équipe analytique est qualifiée pour la réalisation des analyses libératoires, des études de stabilité et de la caractérisation de vos procédés.
Chez ABL, nous sommes convaincus que la définition précoce de la stratégie de contrôle analytique aussi bien que la robustesse des méthodes analytiques sont clé pour la réussite de vos projets.
Si besoin, n’hésitez pas à nous contacter pour nous consulter sans engagement supplémentaire.
SERVICES ANALYTIQUES & METHODES PROPOSEES